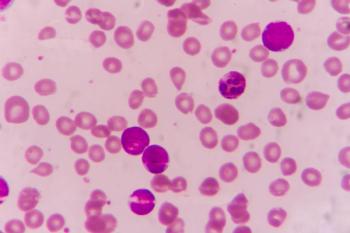

Patients with B-cell non-Hodgkin lymphomas and B-cell acute lymphoblastic leukemia can benefit greatly from chimeric antigen receptor (CAR) T-cell therapy, but providing that therapy has become much more difficult in the age of coronavirus disease 2019 (COVID-19).